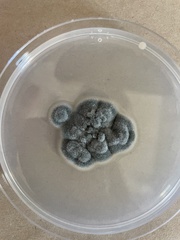
Cladosporium cladosporioides
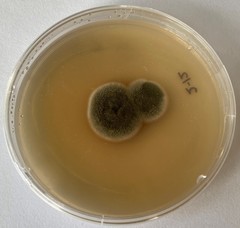
Cladosporium cladosporioides
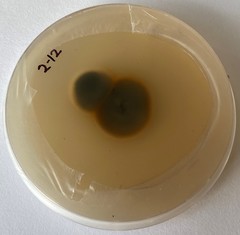
Cladosporium cladosporioides
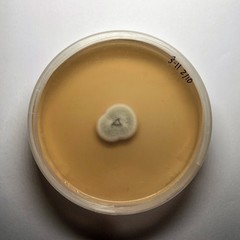
Cladosporium cladosporioides
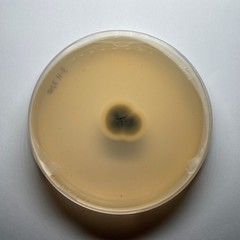
Cladosporium cladosporioides

Cladosporium cladosporioides: taxon details and analytics
- Domain
- Kingdom
- Fungi
- Phylum
- Ascomycota
- Class
- Dothideomycetes
- Order
- Capnodiales
- Family
- Cladosporiaceae
- Genus
- Cladosporium
- Species
- Cladosporium cladosporioides
- Scientific Name
- Cladosporium cladosporioides
Summary description from Wikipedia:
Cladosporium cladosporioides
Cladosporium cladosporioides is a darkly pigmented mold that occurs world-wide on a wide range of materials both outdoors and indoors.
It is known for its role in the decomposition of organic matter and its presence in indoor and outdoor environments. This species is also notable for its potential impact on human health, particularly in individuals with respiratory conditions.
It is one of the most common fungi in outdoor air where its spores are important in seasonal allergic disease. While this species rarely causes invasive disease in animals, it is an important agent of plant disease, attacking both the leaves and fruits of many plants. This species produces asexual spores in delicate, branched chains that break apart readily and drift in the air. It is able to grow under low water conditions and at very low temperatures.
...Cladosporium cladosporioides in languages:
- Bokmål
- småsporet kondensmugg
- Czech
- čerň černá
Images from inaturalist.org observations:
We recommend you sign up for this excellent, free service.
Parent Taxon
Sibling Taxa
- Cladosporium aecidiicola
- Cladosporium allicinum
- Cladosporium allii
- Cladosporium alneum
- Cladosporium arthropodii
- Cladosporium atriellum
- Cladosporium auriculae
- Cladosporium austrohemisphaericum
- Cladosporium brunneoatrum
- Cladosporium butyri
- Cladosporium chamaeropis
- Cladosporium citri
- Cladosporium cladosporioides
- Cladosporium colocasiae
- Cladosporium crousii
- Cladosporium cucumerinum
- Cladosporium cycadicola
- Cladosporium echinulatum
- Cladosporium epichloes
- Cladosporium eriobotryae
- Cladosporium fasciculare
- Cladosporium fraxinicola
- Cladosporium herbarum
- Cladosporium hillianum
- Cladosporium hypophyllum
- Cladosporium iridis
- Cladosporium lacroixii
- Cladosporium licheniphilum
- Cladosporium lophodermii
- Cladosporium macrocarpum
- Cladosporium maculans
- Cladosporium magnusianum
- Cladosporium nigrellum
- Cladosporium oncobae
- Cladosporium oxysporum
- Cladosporium perangustum
- Cladosporium pericarpium
- Cladosporium phlei
- Cladosporium phyllophilum
- Cladosporium polygonati
- Cladosporium pseudiridis
- Cladosporium ramotenellum
- Cladosporium sinuosum
- Cladosporium sphaerospermum
- Cladosporium spongiosum
- Cladosporium syringae
- Cladosporium tenuissimum
- Cladosporium trillii
- Cladosporium trilliicola
- Cladosporium typhae
- Cladosporium uredinicola
- Cladosporium variabile
- Cladosporium vicinum
- Cladosporium vincicola
- Cladosporium xylophilum
- Davidiella carinthiaca